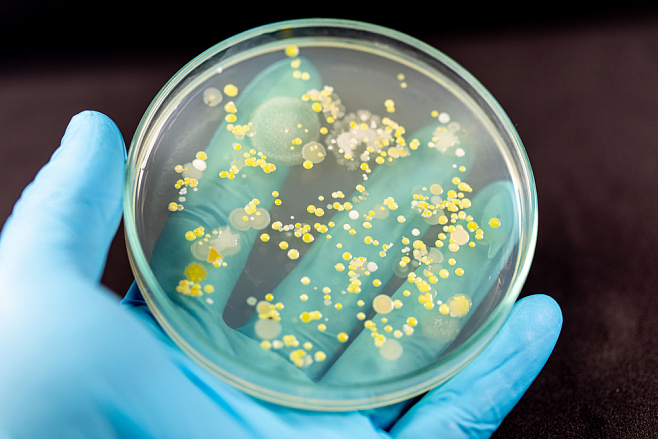

Как снизить углеродный след горнодобывающих предприятий и сэкономить?

Один из основных методов снижения количества углекислого газа в воздухе на территориях отработанных промышленных карьеров — восстановление лесов. Быстрорастущие кустарники и деревья позволяют эффективно перерабатывать углерод из земли и воздуха. В первую очередь высаживаются облепиха и ракита, затем — деревья мелколиственных пород, например осина и береза. Особенность такой посадки в том, что флора накапливает до 4 тонн биомассы на гектар в год за счет CO2 в атмосфере. Кроме того, способ позволит снизить углеродный след при самовозгорании отработанных породных отвалов.
При разработке торфяных месторождений необходимо проводить рекультивацию выработанных пространств — заболачивание задерживает углекислый газ в донных отложениях. Важную роль в этом играет почвенная микрофлора болот, которая расщепляет метан и оксид азота.
Наиболее перспективной методикой для горнодобывающих предприятий исследователи считают технологию прямого захвата вредного газа у точки выброса. В фотобиореактор подается газовоздушная смесь с повышенным содержанием CO2, которую в результате фотосинтеза поглощают микроводоросли Chlorella kessleri, наращивая биомассу. Способ позволяет получать из водорослей различные виды возобновляемого биотоплива: биодизель и биоводород. С помощью микроводорослей можно также очистить сточные воды от тяжелых металлов и биоразлагаемых неорганических соединений. Анаэробные бактерии, находящиеся в специализированных прудах, фотобиореакторах и ферментерах, преобразуют органические вещества в биогаз, который используется для внутреннего электро- и теплоснабжения предприятия.
С углублением горных работ увеличивается относительная и абсолютная газообильность шахт. Для решения вопросов промышленной и экологической безопасности исследователи предлагают закачивать метанокисляющие бактерии в составе рабочих суспензий в подземные пласты с помощью компрессоров. Методы позволят устранять парниковые газы напрямую из мест накопления; ученые утверждают, что этот способ снизит выбросы метана в атмосферу в 2 раза.
«Биотопливо, созданное на основе возобновляемых растительных источников, при внедрении в угледобывающие предприятия позволит значительно снизить использование угля, нефти и природного газа, сократив техногенный углеродный след. При производстве биотоплива используется углекислый газ, ранее поглощенный растениями во время роста, то есть благодаря чему процесс замкнутый и экологически устойчивый, — объясняет старшая преподавательница кафедры безопасности и экологии горного производства НИТУ МИСИС Александра Куликова, — На основе математических моделей и анализа биохимических процессов мы продемонстрировали, что анаэробные микроорганизмы и быстрорастущие растения могут стать эффективным инструментом для сокращения углеродного следа в угледобывающей промышленности. Предложенные технологии позволят снизить выбросы парниковых газов и создавать из диоксида углерода полезные продукты».
В аналитическом исследовании, опубликованном в научном журнале Sustainable Development of Mountain Territories (Q2), ученые опирались на опыт российских и зарубежных компаний.
Технологии
Пресс-служба НИТУ МИСИС